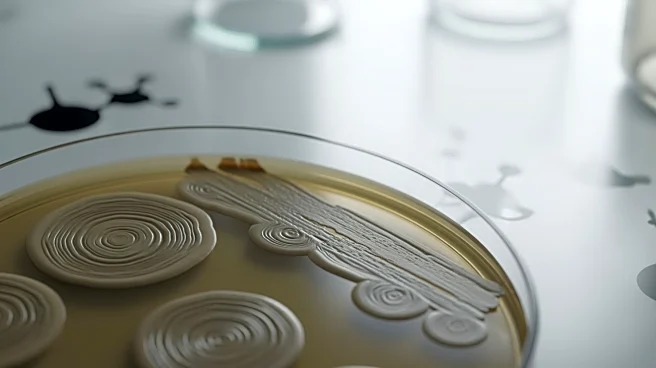
Nature Study Explores Vaccine Competence in Candida Albicans Strains

What's Happening?
A recent study published in Nature has characterized dual DNA polymerase knockout strains of Candida albicans, focusing on their competence as live whole-cell vaccines. The research involved generating
knockout strains by deleting specific genes, POL32 and RAD30, using a modified SAT1 flipper strategy. These strains were tested for growth, temperature sensitivity, and response to genotoxic agents. The study also examined the strains' morphology, phagocytosis, and immune response in a murine model. The findings suggest that these knockout strains could serve as potential candidates for developing vaccines against systemic candidiasis, a severe fungal infection.
Why It's Important?
The study's findings are significant as they offer insights into developing new vaccines for systemic candidiasis, a condition that poses a serious health risk, especially to immunocompromised individuals. By understanding the genetic modifications that enhance vaccine competence, researchers can potentially create more effective treatments. This could lead to improved public health outcomes and reduce the burden on healthcare systems. The research also contributes to the broader field of immunology and vaccine development, providing a foundation for future studies on fungal infections and their prevention.
What's Next?
Further research is needed to validate the efficacy of these knockout strains as vaccines in larger and more diverse populations. Clinical trials could be conducted to assess safety and effectiveness in humans. Additionally, exploring the genetic mechanisms behind the strains' vaccine competence could lead to advancements in genetic engineering and biotechnology. Collaboration between researchers, healthcare providers, and pharmaceutical companies will be crucial in advancing these findings from the laboratory to real-world applications.
Beyond the Headlines
The study raises ethical considerations regarding genetic modifications and their implications for vaccine development. It also highlights the importance of maintaining high ethical standards in animal research, as demonstrated by the study's adherence to institutional ethical guidelines. The potential for these findings to influence public health policy and vaccine strategies underscores the need for ongoing dialogue between scientists, policymakers, and the public.